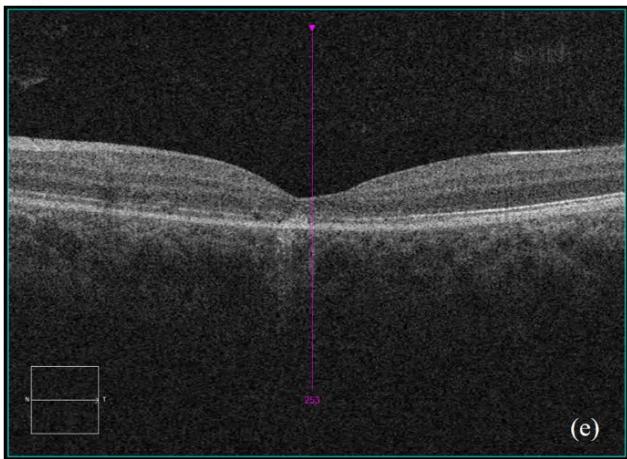

This case report describes a temporal relationship of unilateral neuroretinitis following the second Pfizer-BioNTech COVID-19 (Pfizer) vaccine. A 16-year-old male of mixed ethnicity presented with gradual loss of vision and pain on eye movement in his left eye 12 days after his second Pfizer vaccine. His visual acuity in the left eye was count fingers at half a meter. There was optic nerve head swelling, macular exudates in a star-shaped pattern with peripapillary and foveal subretinal fluid consistent with left neuroretinitis. His serological and radiologic investigations were negative for any alternative aetiology. He was commenced on doxycycline, rifampicin and oral prednisone on a tapering dose. 4 months after presentation his left eye vision improved to 6/24-2; limited by loss to the outer retinal layers over the fovea. The close proximity of the second Pfizer vaccine dose poses a temporal association with plausible causation.
## I. INTRODUCTION
Succcessive vaccination against severe acute respiratory syndrome coronavirus 2 (SARS-CoV-2) formed one of the primary public health strategies during the COVID-19 pandemic. Pfizer-BioNTech COVID-19 (Pfizer), is the nationally approved and disseminated vaccine in New Zealand (NZ). This mRNA vaccine is provided as an intramuscular injection with two sequential doses required at a 3-4 week interval to achieve satisfactory immunogenicity. Due to the relative infancy of Pfizer's commercial use, its ocular side effect profile is continuing to emerge, particularly from anecdotal accounts. This case report describes a temporal relationship of unilateral neuroretinitis following the second Pfizer vaccine, providing evidence for a potentially rare vaccine-related side-effect.
## II. CASE REPORT
A 16-year-old male of Maori, Pacific Islander and NZ European background, presented to a regional ophthalmology service with a 12-day history of gradual vision loss in his left eye and pain on eye movement.
Review of systems was negative, with no constitutional symptoms. He had limited exposure to farm animals with no direct exposure to domestic animals such as cats. He was not sexually active, denied intravenous drug use and had no history of overseas travel. However, he recently had two successive doses of the Pfizer-BioNTech COVID-19, with his second vaccination 24 days prior to presentation and 12 days prior to symptom onset.
On examination, his visual acuity in the right eye was 6/4.5 while his left eye was counting fingers. His intraocular pressures were $16\mathrm{mmHg}$ and $10\mathrm{mmHg}$ in his right and left eye respectively. He had a grade III left relative afferent pupillary defect (RAPD). Whilst he had full range of eye movement, there was pain on moving his left eye. His left optic nerve was grossly swollen with a macular star (figure 1). There was no anterior chamber inflammation or vitritis. Optical coherence of the retinal nerve fibre layer (OCT RNFL) assessment showed an average RNFL thickness of $481\mu \mathrm{m}$, with peripapillary subretinal fluid extending to the fovea (figure 2). Automated perimetry demonstrated an early central scotoma in the left visual field with mean deviation (MD) -4.35 dB. He had a normal right ocular examination and ancillary investigations. Clinical examination and investigations were consistent with left neuroretinitis.

 Figure 1: Fundus photography of right eye (a) and left eye (b). The left eye demonstrates diffuse optic nerve head swelling with macular hard-exudates in a star pattern characteristic of left neuroretinitis.
 Macula Thickness OU: Macular Cube 512x128 OD OS Fovea:250,65



 (a)
 (b)


 350 175 0μ





 Figure 2: Zeiss OCT macular $512 \times 128$ cube (a) and disc RNFL $200 \times 200$ cube (b) of both eyes. The left eye demonstrates optic nerve head oedema (b) with peripapillary and foveal subretinal fluid (a).
The patient's infectious screen was negative. This included; Quantiferon-TB Gold, Syphilis, Bartonella henselae immunoglobulin G (IgG)/immunoglobulin M (IgM), human immunodeficiency virus (HIV) antigen and antibody (Ag/Ab), cytomegalovirus (CMV) IgG/IgM, Toxoplasma IgG/IgM and Leptospiral IgM enzyme-linked immunosorbent assay (ELA). Serum angiotensin converting enzyme (ACE) and chest x-ray were normal. Lyme disease serology (Borrelia burgdorferi) was not tested as he had not travelled outside of NZ. Bartonella henselae serology was negative when sequentially tested on initial presentation as well as 4 and 8 weeks later. He had a normal full blood count, liver function, renal function, serum folate and B12. His antinuclear antibodies (ANA) were weakly positive and inconclusive with negative extractable nuclear antigen (ENA), antineutrophil cytoplasmic antibodies (ANCA) and double-stranded deoxyribonucleic acid 40 (dsDNA). Neuromyelitis optica (NMO) IgG antibodies were initially positive however negative on repeat testing 4 weeks
later including negative myelin oligodendrocyte glycoprotein (MOG) antibodies. Magnetic resonance imaging (MRI) of the head, orbits and spine with gadovist contrast were consistent with left retrobulbar optic neuritis without intracranial or spinal involvement (figure 3).

 Figure 3: MRI head and orbits with (a); T2 axial TSE FLAIR sequence and (b); T1 coronal TSE Dixon sequence with contrast. Focal enhancement of the anterior margin of the left optic nerve at its junction with the globe is demonstrated without other demyelination or parenchymal intracranial pathology.
The patient was discussed with infectious disease and neurology subspecialties and subsequently commenced on doxycycline $100\mathrm{mg}$ twice a day, rifampicin $300\mathrm{mg}$ twice a day and oral prednisone $60\mathrm{mg}$ daily tapered by $10\mathrm{mg}$ per week over for a total of six weeks. He was also supplemented with Vitamin D3. The patient's retrobulbar pain improved within a week of treatment commencement. His best-corrected vision improved to 6/24-2 four months after presentation. His RAPD resolved completely however due to subfoveal outer retinal disruption he continued to demonstrate reduced vision (figure 4e). The optic nerve head swelling improved with resolution of peripapillary and foveal subretinal fluid. His macular hard exudates, previously in a star-shaped pattern, also improved, as did his early visual field defect on automated perimetry. The patient remains under the care of ophthalmology and neurology outpatient departments with ongoing follow-up at time of publishing.

Figure 4: Clinical status 4-months following treatment. (a) Right eye fundus photo, (b) left eye fundus photo, OCT macular cube (c) and OCT RNFL analysis demonstrating improvement of optic nerve head swelling, peripapillary and subfoveal subretinal fluid. (e) Enlarged OCT macular cube demonstrating outer retinal layer loss at the fovea contributing to persistent low vision.
## III. DISCUSSION
An increasing number of case reports and retrospective case studies have emerged detailing possible adverse effects of vaccination against COVID-19. These appear to encompass a wide variety of ophthalmic manifestations; including orbital, corneal, uveitic, retinal and neurological disorders. Given the strong association between uveitis and immunologic phenomena, a relationship between vaccination and uveitis would be expected. Pavesio et al. identified 70 patients presenting with ocular inflammatory events within 14 days following COVID-19 vaccination with a mean age of 51 years. Elhusseiny et al. reviewed fourteen reports involving 34 patients reporting uveitis after COVID-19 vaccination. The average age at the time of presentation was $47.6 \pm 16.3$ years, with the average time from vaccination to development of ophthalmic symptoms $8.0 \pm 8.6$ days.
In a review of adverse ocular events from 2010 to 2020, optic neuritis was found to be the most common event associated with nine different vaccines with a mean onset of 10.8 days post- injection. Five patients receiving COVID-19 vaccination were diagnosed with post-vaccination central nervous system inflammatory syndrome leading to neuroretinitis and papillitis. The mean age at the time of presentation was $48.0 \pm 21.5$ years, and the average time from vaccination to development of ophthalmic symptoms was $8.6 \pm 8.3$ days. Three of them presented with bilateral involvement. Significant improvement in symptoms and examination was achieved with use of intravenous methylprednisolone. $^{3}$
Neuroretinitis is a focal inflammatory optic neuropathy characterised by unilateral optic disc oedema and macular exudates. Both infectious and non-infectious aetiologies are recognised with Cat-Scratch Disease (Bartonella henselae) being the most common identifiable cause. The patient presented had serial tests for Bartonella henselae with IgG titres being consistently $< 64$ with negative IgM results. Approximately $25\%$ of neuroretinitis cases are considered idiopathic where no definitive cause is determined after thorough investigation. The close proximity of the second Pfizer vaccine dose poses a temporal association with plausible causation. The patient was neither symptomatic nor tested positive to SARS-CoV-2 preceding onset of his ocular symptoms. Lee et al, described a similar case-report of unilateral neuroretinitis of an 83-year old Korean woman following her second dose of the Pfizer vaccine. Visual loss, to the point of hand-movement perception, occurred two days after receiving the second Pfizer vaccine with no background primary ocular history. She was commenced on three days of 1g intravenous methylprednisolone, followed by oral prednisone taper. Although initial visual improvement was witnessed during the first month of treatment, her vision remained finger-counting perception after six months. Lee et al postulated that the low vision was at least partly due to photoreceptor disruption due to persistent subretinal fluid.8 Likewise, whilst there was considerable improvement to vision and status of the disc and macula in our patient over a four-month period, his visual acuity remained at 6/24-2 secondary to continued sub foveal photoreceptor disruption. Of note, in contrast to the case presented by Lee et al our patient had the typical clinical features of neuroretinitis with the presence of a macular star. Although the demographics and visual outcomes of the two cases may differ, they share an interesting temporal similarity of ocular disease following the second Pfizer vaccine dose. Cheng and Margo et al, suggested that vaccine-related side effects, particularly within close proximity of initial administration may be attributable to an immediate hypersensitivity-type reaction.9 As the Pfizer vaccine is still relatively novel with respect to its known ocular side-effect profile, this case report poses a temporal relationship with high plausibility. Case reports such as these provide important insight to potential rare-side-effects of a widely disseminated global vaccine.
### Disclosure statements
The authors have no conflicts of interest to declare.
### Statement of Ethics
Informed consent was obtained from the patient for publication of the details of their medical case and any accompanying images. Outside the participant's informed consent, ethical approval was not required in accordance with local guidelines and policy.
### Conflict of Interest Statement
The authors have no conflicts of interest to declare.
### Funding Sources
There are no external funding or sponsorships to declare.
Generating HTML Viewer...
References
9 Cites in Article
Manatu Hauora,Ministry Health (2022). COVID-19 vaccines.
F Polack,S Thomas,N Kitchin,J Absalon,A Gurtman,S Lockhart (2020). Safety and Efficacy of the BNT162b2 mRNA Covid-19 Vaccine.
Ilaria Testi,Camilo Brandão-De-Resende,Rupesh Agrawal,Carlos Pavesio (2022). Ocular inflammatory events following COVID-19 vaccination: a multinational case series.
Rim Kahloun,Imen Khairallah-Ksiaa,Nesrine Abroug,Anis Mahmoud,Salim Ben Yahia,Sonia Zaouali,Bechir Jelliti,Moncef Khairallah (2015). Final Diagnosis in Patients Referred with a Diagnosis of Neuroretinitis.
Dean Wingerchuk,Brenda Banwell,Jeffrey Bennett,Philippe Cabre,William Carroll,Tanuja Chitnis,Jérôme De Seze,Kazuo Fujihara,Benjamin Greenberg,Anu Jacob,Sven Jarius,Marco Lana-Peixoto,Michael Levy,Jack Simon,Silvia Tenembaum,Anthony Traboulsee,Patrick Waters,Kay Wellik,Brian Weinshenker (2015). International consensus diagnostic criteria for neuromyelitis optica spectrum disorders.
Chaeyeon Lee,Kyung-Ah Park,Don-Il Ham,Minjung Seong,Hyung-Jin Kim,Ga-In Lee,Sei Oh (2022). Neuroretinitis after the second injection of a SARS-CoV-2-vaccine: A case report.
Y Cheng,C Margo (2022). Ocular adverse events following vaccination: overview and update.
No ethics committee approval was required for this article type.
Data Availability
Not applicable for this article.
How to Cite This Article
Louis Antoine Bonnet. 2026. \u201cUnilateral Idiopathic Neuroretinitis Following Pfizer-BioNTech COVID-19 Vaccine; A Case Report\u201d. Global Journal of Medical Research - F: Diseases GJMR-F Volume 23 (GJMR Volume 23 Issue F3): .
Explore published articles in an immersive Augmented Reality environment. Our platform converts research papers into interactive 3D books, allowing readers to view and interact with content using AR and VR compatible devices.
Your published article is automatically converted into a realistic 3D book. Flip through pages and read research papers in a more engaging and interactive format.
This case report describes a temporal relationship of unilateral neuroretinitis following the second Pfizer-BioNTech COVID-19 (Pfizer) vaccine. A 16-year-old male of mixed ethnicity presented with gradual loss of vision and pain on eye movement in his left eye 12 days after his second Pfizer vaccine. His visual acuity in the left eye was count fingers at half a meter. There was optic nerve head swelling, macular exudates in a star-shaped pattern with peripapillary and foveal subretinal fluid consistent with left neuroretinitis. His serological and radiologic investigations were negative for any alternative aetiology. He was commenced on doxycycline, rifampicin and oral prednisone on a tapering dose. 4 months after presentation his left eye vision improved to 6/24-2; limited by loss to the outer retinal layers over the fovea. The close proximity of the second Pfizer vaccine dose poses a temporal association with plausible causation.
Our website is actively being updated, and changes may occur frequently. Please clear your browser cache if needed. For feedback or error reporting, please email [email protected]
Thank you for connecting with us. We will respond to you shortly.